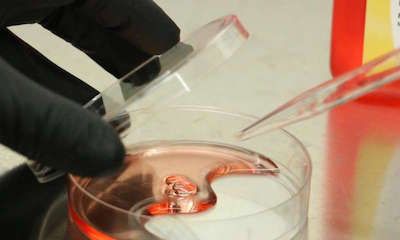

夏威夷大学John A. Burns医学院和Cardax公司最近联合公布了一项动物研究的结果,他们对一种抗衰老药物的有效性进行了评估。由Cardax公司开发的虾青素化合物CDX-085能够显著增强FOXO3基因的表达,之前有研究表明该基因与长寿有关。“每个人体内都有FOXO3基因,可以帮助人类对抗衰老,但是每三个人中可能就有一人体内携带另一种与长寿有关的FOXO3。通过激活普通人体内的FOXO3基因,我们就可以将其变成‘长寿’版的FOXO3。通过该研究我们证明了虾青素能够激活FOXO3基因。”Bradley Willcox教授这样说道。这项初步研究首次在动物体内检测了虾青素对FOXO3基因的激活能力。在该研究中,研究人员用正常食物或包含了低剂量或高剂量虾青素化合物CDX-085的食物喂养小鼠,结果发现食物中含有更高剂量虾青素化合物的小鼠在其心脏组织中出现了FOXO3基因的表达增强。“夏威夷大学的这项突破性发现进一步支持了虾青素对健康的有益作用,也解释了为何一些健康保健团体非常推崇虾青素,”Cardax公司CEO David G. Watumull这样说道。“我们希望能够在临床试验中进一步证实虾青素的抗衰老作用。”“能够与Cardax公司在这个非常具有前景的项目上进行合作让我们感到非常满意,该研究或可帮助延缓人类衰老。这也是夏威夷创新计划的一个很好的例子,在该项目的联合之下私营企业与政府能够共同推动创新、研究、教育等方面,从而使经济实现多样化。”来自夏威夷大学的Vassilis L. Syrmos这样说道。
夏威夷大学John A. Burns医学院和Cardax公司最近联合公布了一项动物研究的结果,他们对一种抗衰老药物的有效性进行了评估。由Cardax公司开发的虾青素化合物CDX-085能够显著增强FOXO3基因的表达,之前有研究表明该基因与长寿有关。“每个人体内都有FOXO3基因,可以帮助人类对抗衰老,但是每三个人中可能就有一人体内携带另一种与长寿有关的FOXO3。通过激活普通人体内的FOXO3基因,我们就可以将其变成‘长寿’版的FOXO3。通过该研究我们证明了虾青素能够激活FOXO3基因。”Bradley Willcox教授这样说道。这项初步研究首次在动物体内检测了虾青素对FOXO3基因的激活能力。在该研究中,研究人员用正常食物或包含了低剂量或高剂量虾青素化合物CDX-085的食物喂养小鼠,结果发现食物中含有更高剂量虾青素化合物的小鼠在其心脏组织中出现了FOXO3基因的表达增强。“夏威夷大学的这项突破性发现进一步支持了虾青素对健康的有益作用,也解释了为何一些健康保健团体非常推崇虾青素,”Cardax公司CEO David G. Watumull这样说道。“我们希望能够在临床试验中进一步证实虾青素的抗衰老作用。”“能够与Cardax公司在这个非常具有前景的项目上进行合作让我们感到非常满意,该研究或可帮助延缓人类衰老。这也是夏威夷创新计划的一个很好的例子,在该项目的联合之下私营企业与政府能够共同推动创新、研究、教育等方面,从而使经济实现多样化。”来自夏威夷大学的Vassilis L. Syrmos这样说道。原始出处:Astaxanthin compound found to switch on the FOX03 'longevity gene' in mice






